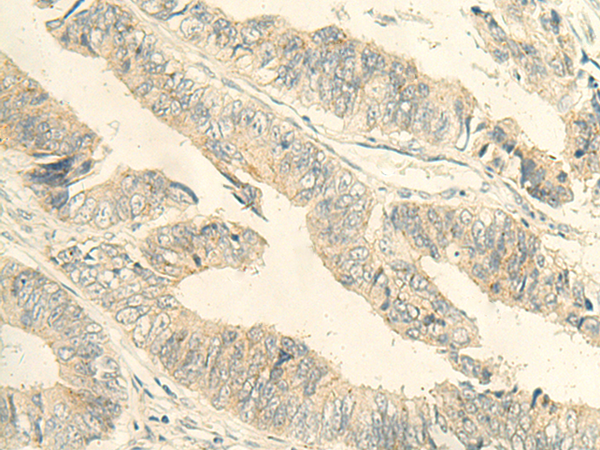

|
Background: |
This gene encodes a member of the C-type lectin/C-type lectin-like domain (CTL/CTLD) superfamily. Members of this family share a common protein fold and have diverse functions, such as cell adhesion, cell-cell signalling, glycoprotein turnover, and roles in inflammation and immune response. The encoded type 2 transmembrane protein may function as a cell surface antigen. Two transcript variants encoding distinct isoforms have been identified for this gene. |
|
Applications: |
ELISA, IHC |
|
Name of antibody: |
CLEC10A |
|
Immunogen: |
Fusion protein of human CLEC10A |
|
Full name: |
C-type lectin domain containing 10A |
|
Synonyms: |
HML; MGL; HML2; CD301; CLECSF13; CLECSF14 |
|
SwissProt: |
Q8IUN9 |
|
ELISA Recommended dilution: |
5000-10000 |
|
IHC positive control: |
Human tonsil |
|
IHC Recommend dilution: |
40-200 |
購(gòu)物車
幫助
021-54845833/15800441009
